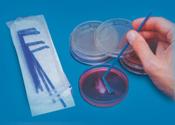
एल आकार का स्प्रेडर बाँझ

एल शेप्ड स्प्रेडर
प्राइस: 50 INR
नवीनतम कीमत पता करें
स्टॉक में
| प्रॉडक्ट टाइप | L Shaped Spreader |
| मटेरियल | Plastic |
| वज़न | 50-100 |
| टाइप करें | Spreader |
| डिस्प्ले टाइप | 36X 18 X 2 |
विस्तृत जानकारी
| प्रॉडक्ट टाइप | L Shaped Spreader |
| मटेरियल | Plastic |
| वज़न | 50-100 |
| टाइप करें | Spreader |
| डिस्प्ले टाइप | 36X 18 X 2 |
| पैकेजिंग का विवरण | Wooden Box |
| आपूर्ति की क्षमता | 10-15प्रति सप्ताह |
| भुगतान की शर्तें | कैश एडवांस (CA), कैश ऑन डिलीवरी (COD), कैश इन एडवांस (CID), चेक |
| डिलीवरी का समय | 10-15दिन |
| मुख्य घरेलू बाज़ार | ऑल इंडिया |
| मुख्य निर्यात बाजार | पश्चिमी यूरोप, ऑस्ट्रेलिया, पूर्वी यूरोप, मिडल ईस्ट, दक्षिण अमेरिका, मध्य अमेरिका, उत्तरी अमेरिका, अफ्रीका, एशिया |
| नमूना नीति | यदि आदेश की पुष्टि हो जाती है तो हम नमूना लागत की प्रतिपूर्ति करेंगे |
| नमूना उपलब्ध | 1 |
कंपनी का विवरण
ह. ल. साइंटिफिक इंडस्ट्रीज, 1963 में हरयाणा के अंबाला कैंट में स्थापित, भारत में वैज्ञानिक उपकरण का टॉप सेवा प्रदाता है। ह. ल. साइंटिफिक इंडस्ट्रीज, ट्रेड इंडिया के सूचीबद्ध सेवाओं के लिए के सत्यापित और विश्वसनीय नामों में से एक है। वैज्ञानिक उपकरण के क्षेत्र में अपने व्यापक अनुभव के साथ, ह. ल. साइंटिफिक इंडस्ट्रीज ने उच्च गुणवत्ता आदि के साथ बाजार में अपने लिए एक प्रतिष्ठित नाम बनाया है। ग्राहक केंद्रित दृष्टिकोण पर ध्यान केंद्रित करते हुए, ह. ल. साइंटिफिक इंडस्ट्रीज की अखिल भारतीय उपस्थिति है और पूरे देश में एक विशाल उपभोक्ता आधार को पूरा करता है। ट्रेड इंडिया गुणवत्ता-सुनिश्चित सेवाओं पर ह. ल. साइंटिफिक इंडस्ट्रीज से वैज्ञानिक उपकरण सेवाएं प्राप्त करें। ग्राहक केंद्रित दृष्टिकोण पर ध्यान केंद्रित करते हुए, ह. ल. साइंटिफिक इंडस्ट्रीज की अखिल भारतीय उपस्थिति है और पूरे देश में एक विशाल उपभोक्ता आधार को पूरा करता है। ट्रेड इंडिया गुणवत्ता-सुनिश्चित सेवाओं पर ह. ल. साइंटिफिक इंडस्ट्रीज से वैज्ञानिक उपकरण सेवाएं प्राप्त करें।
व्यापार के प्रकार
निर्माता, निर्यातक, सेवा प्रदाता, वितरक, आपूर्तिकर्ता, व्यापार कंपनी, थोक विक्रेता, खुदरा विक्रेता, विक्रेता, फेब्रिकेटर, उत्पादक
कर्मचारी संख्या
12
स्थापना
1963
कार्य दिवस
सोमवार से शनिवार
जीएसटी सं
06AVHPG9441R1ZX
Explore in english - L Shaped Spreader
विक्रेता विवरण
ह. ल. साइंटिफिक इंडस्ट्रीज
जीएसटी सं
06AVHPG9441R1ZX
नाम
धीरज गोस्वामी
पता
५४ नई कॉलोनी अपोजिट इंडस्ट्रियल एरिया अंबाला कैंट, हरयाणा, 133006, भारत
गलत विवरण की रिपोर्ट करें
संबंधित उत्पाद
कलर करेक्टेड इन्फिनिटी ऑप्टिकल सिस्टम के साथ फ्लोरेसेंस माइक्रोस्कोप
MOQ - 1 Number
रेडिकल साइंटिफिक इक्विपमेंट्स पवत. ल्टड.
अंबाला कैंट, Haryana